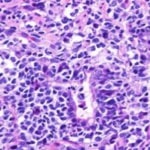

消化器科
慢性的な下痢・嘔吐
診断手順
- ☆身体検査
- ☆糞便検査
- ☆血液検査
- ☆レントゲン検査
![]()
>> 異常が見つからない場合 >>
- ★バリウム検査
- ★超音波検査
- ★内視鏡検査
- ★胃・腸の生検
などの検査を行うことで、嘔吐・下痢の原因の早期診断につながり、診断結果に応じて治療を行っていきます。慢性的な下痢、嘔吐でお悩みの方はどうぞご相談ください。
症例1:腸内異物
ボーダーコリー 9ヵ月 オス
主訴:食欲、元気はあるが食後2時間で未消化物を嘔吐。異物癖あり。
触診上、下腹部に5cm大の硬結物を確認。
◎各種検査結果
- ・血液検査:低カリウム血症
- ・レントゲン検査:胃ガス、腸内ガス陰影、空腸領域に不透過性の陰影あり。

- ・バリウム造影検査:造影後2時間、胃からのバリウム排泄なし。

- 上記検査結果より、同日、内視鏡検査ならびに腸内異物摘出術を実施。
- 内視鏡検査:胃内にて4cm大のロープ様の異物を摘出。胃内、十二指腸内に炎症像が認められた。
◎腸内異物摘出術
本症例は、 おもちゃのロープを誤飲したことにより腸で通過障害を引き起こし、嘔吐として症状が認められた。現在のところ、一般状態に問題なく経過観察を指示。
症例2:リンパ管拡張症
ブルドッグ 6歳 オス
主訴:2週間以上続く水様性下痢。体重減少。
◎各種検査結果
- 糞便検査:寄生虫(−)
- 血液検査;低Alb血症
- 経過が長いことならびに一般的な治療への反応が乏しいため、内視鏡検査を実施しました。
◎内視鏡検査結果
◎治療方針
- 内科療法(プレドニゾロン・抗生剤・整腸剤)
- 食事療法(低脂肪食を中心としたもの)
- 本症例は、内視鏡検査の実施によりIBDと呼ばれる炎症性腸疾患に伴うリンパ管拡張症ということが確定され治療方針の決定に至りました。現在、内服ならびに食事療法により、症状は改善されています。本疾患は、慢性消化器疾患であり、一生涯に渡り食事療法を中心とした管理が必要となります。
症例3:腸内異物(ヒモ状異物)
雑種猫 4歳 オス
主訴:2時間ごとの嘔吐
◎各種検査結果
・血液検査:著変なし
・レントゲン検査:腸内ガス陰影重度
・バリウム像影検査:造影後2時間、胃からのバリウム排泄なし上記検査結果より、内視鏡検査実施。
・内視鏡検査結果:胃内炎症性病変あり。胃の幽門部から十二指腸領域に向かいヒモ状異物確認。
内視鏡検査結果より、十二指腸領域へのヒモ状異物の可能性があるため、同日腸内異物摘出術実施。
腸内異物摘出術
腸管のアコーディオン様所見

腸内異物摘出
摘出した異物
今回の様なヒモ状の異物は、腸の蠕動運動により腸管を傷つけ、発見が遅れると腸穿孔などの重篤な状態を引き起こします。本症例は、術後1週間程で回復し、現在の経過は良好です。
症例5:消化器型リンパ腫
3歳 柴犬 雄
主訴 1年以上続く下痢
◎各種検査結果
・糞便検査:寄生虫(−)
・血液検査:低アルブミン血症
前病院にて、食事療法、抗生剤の投与を行っていましたが改善せず、当院に来院されました。精査のため内視鏡検査を提案しましたが、オーナーの希望によりプレドニゾロンによる試験的治療を開始しました。治療開始後1週間で下痢の改善が見られ、プレドニゾロン同量で継続治療をしていましたが、1ヶ月後に下痢が再発しました。そのためオーナーと相談し、内視鏡による組織生検を実施しました。
◎追加検査
組織生検結果「消化器型リンパ腫」
病理学的所見:十二指腸、回腸、結腸におけるびまん性の糜爛が認められる。粘膜固有層から粘膜上皮にかけて中型から大型のリンパ球がびまん性に浸潤している。
その後、化学療法を行いました。
慢性的な下痢が認められ、低アルブミン血症がある場合、蛋白漏出性腸症が疑われます。蛋白漏出性腸症とは、腸管から何らかの原因によって蛋白が漏出する状態を指します。その原因として、①炎症性腸炎②リンパ管拡張症③消化器腫瘍の3つの疾患、およびこれらの併発が考えられます。若齢の場合③消化器腫瘍の可能性は低いと考えますが、本症例のように柴犬の場合は、慢性下痢には腫瘍が関与していることが他の犬種に比べて多いと言われているため注意が必要です。
症例6:炎症性ポリープ
10歳 M・ダックスフント 去勢雄
主訴 血便
◎各種検査結果
・直腸検査 : 直腸内に腫瘤を確認
1ヶ月以上前から血便が認められるとのことで来院。最近は便の扁平化もみられるとのことでした。直腸検査にて肛門から約3cmの位置に直腸径を半分以上占めるφ1〜2cm大の腫瘤を確認しました。
腫瘤が比較的大きい為、早期の外科的切除を提案しました。術前のCT検査にて腫瘤が孤立性であり肺やリンパ節への明らかな転移像がみられないことを確認した後、直腸腫瘤の切除手術を行いました。
CT画像
◎追加検査
・病理検査結果 「炎症性ポリープ」
病理学的所見 : 多量の粘液を含む拡張した陰窩と肉芽組織の増生、リンパ球や好中球、マクロファージを主体とする炎症細胞の浸潤を認める。悪性所見を示す異型細胞浸潤や増殖は認められない。
術後約1ヶ月頃より徐々に血便やしぶり便症状がみられ始めました。ステロイド療法を開始しましたが反応に乏しかった為シクロスポリンを併用しました。しかしながら直腸検査にて直腸内腫瘤の再発が確認され、症状の悪化も認められました。腫瘤の腫大は著しく、排便時に肛門からの脱出が認められ始めた為、外科療法として直腸粘膜引き抜き術を実施しました。
再手術時写真
術後の経過は良好であり、現在はレフルノミドを用いてコントロールを行っています。
結直腸にみられる炎症性ポリープは、結腸および直腸に限局性にみられる多発性ポリープです。病理所見として強い炎症像がみられ、臨床像からも炎症性腸疾患(IBD)の1種である可能性が考えられています。
本疾患はM・ダックスフントに好発することで知られており、罹患した犬種の半数がM・ダックスフントであったと報告されています。また、他の犬種では結直腸腫瘤全体の約15%しか炎症性ポリープでなかったのに対し、M・ダックスフントでは約75%で認められたとの報告もされています。
本症例のように腫瘤状病変を有する炎症性ポリープは外科療法が必要となることが少なくありませんが、一般的には免疫抑制療法を中心とした内科療法で良好なコントロールができることが多いと言われています。
症例7:胆嚢粘液嚢腫、胆嚢炎
13歳 ボロニーズ 去勢雄
主訴 嘔吐、元気食欲低下
◎ 各種検査結果
- ・ 身体検査:呼吸促迫、粘膜黄色、腹部圧痛
- ・ 血液検査:白血球数増加、好中球左方移動、GPT、ALP、Tbilの上昇
- ・ エコー検査:胆嚢内の筋状高エコー構造物(キウイフルーツ様断面)
以上の結果より、胆嚢粘液嚢腫および、それに伴う胆嚢炎が疑われました。また、エコーにて胆嚢破裂を疑う所見は認められなかったため、入院による内科療法が選択されました。
静脈点滴、抗生剤、鎮痛剤、制吐剤、ウルソデオキシコール酸、グリチルリチン酸にて一週間の入院管理を行いました。また、食事は低脂肪食を選択いたしました。
胆嚢粘液嚢腫において、胆嚢が壊死・破裂し、胆汁成分が流出している場合は外科治療(胆嚢摘出)が適応となる場合があります。本症例では、退院後の症状再発は認められていませんが、定期的な血液検査(肝数値)およびエコー検査を行っています。









































